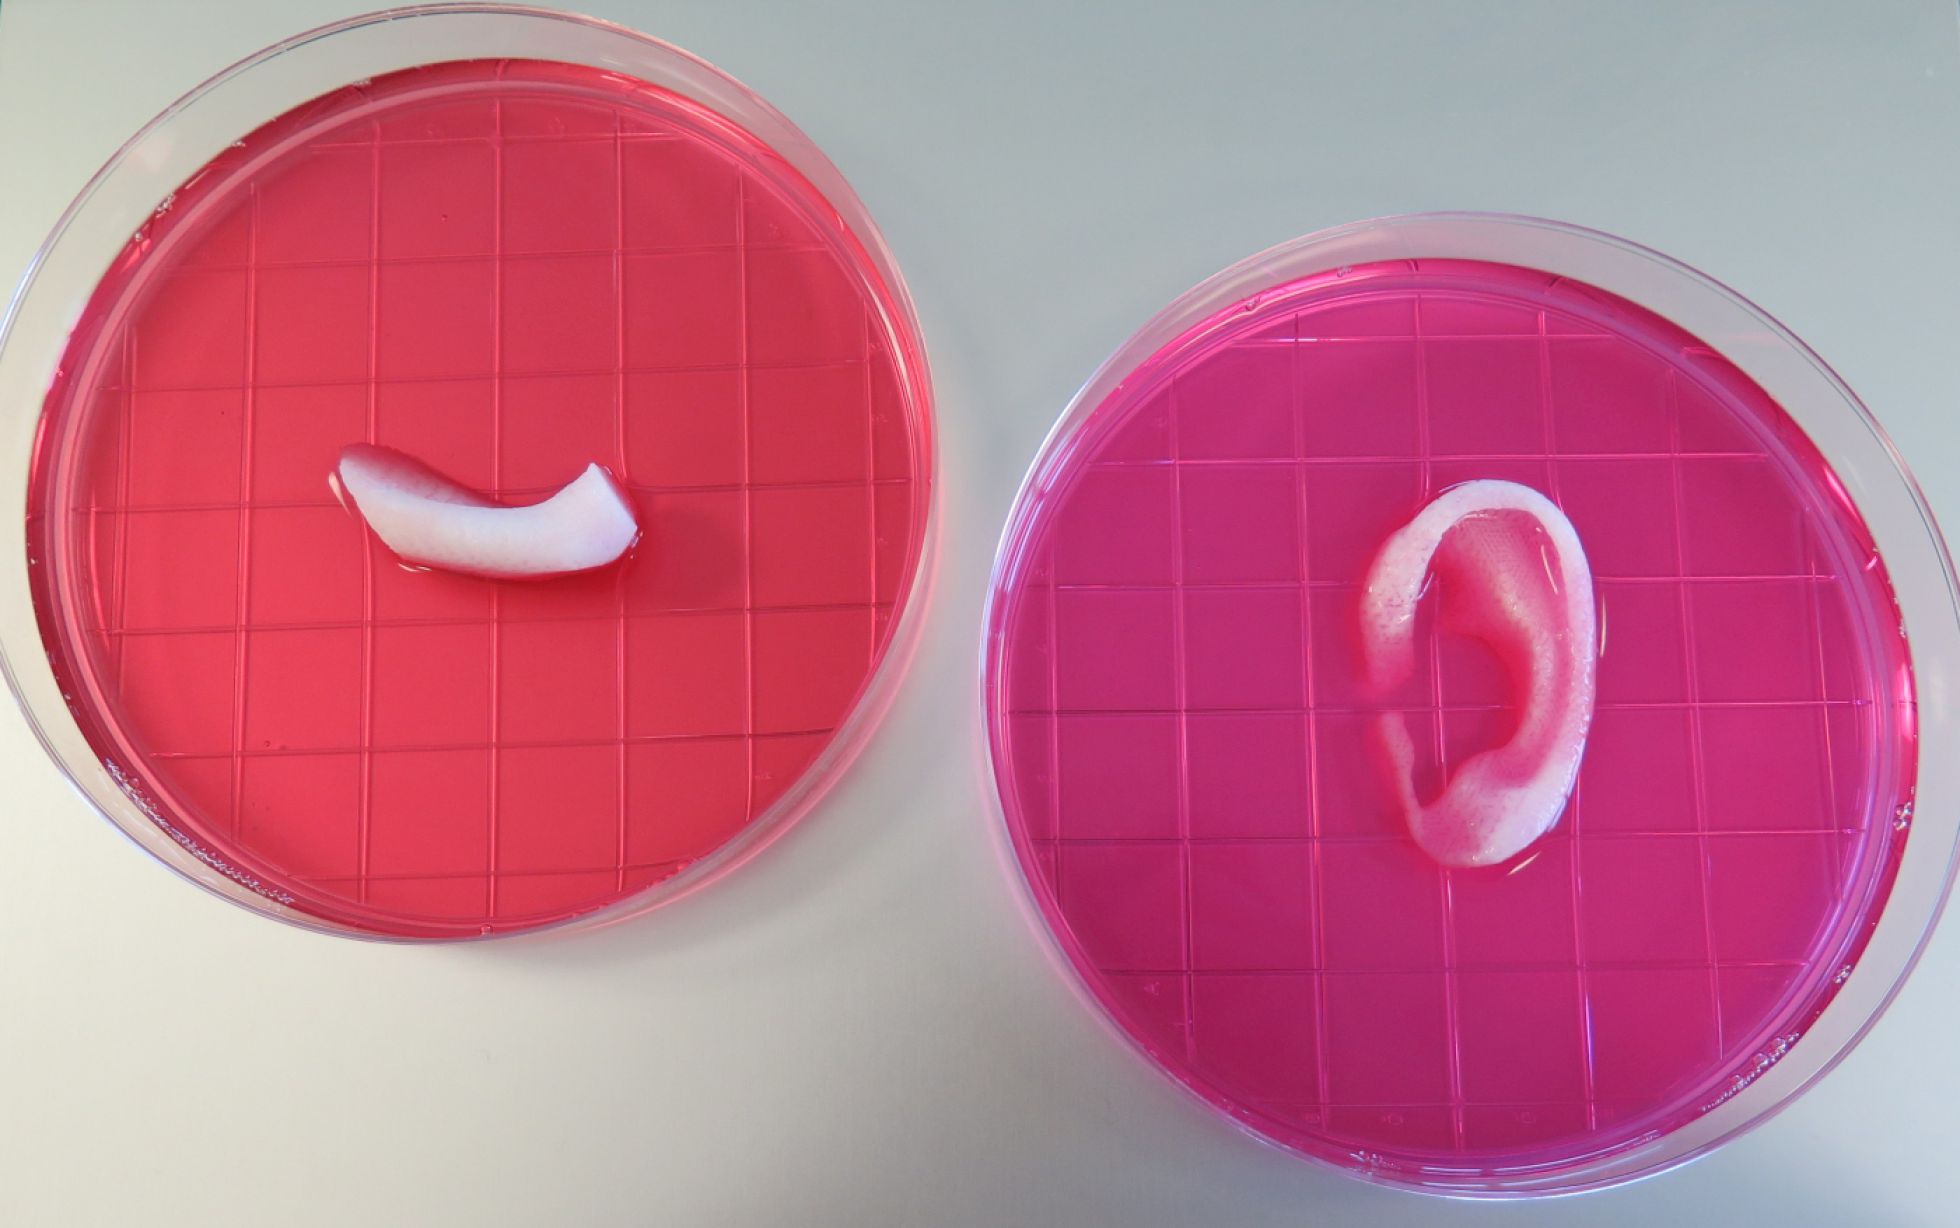
Porción de una mandíbula y oreja impresas con el sistema ITOP Porción de una mandíbula y oreja impresas con el sistema ITOP

Veterinario en Jerez de los Caballeros -- Teléfono 670463944 -- veterinario@justoantonio.es -- www.justoantonio.es
Buscar este blog
viernes, 26 de febrero de 2016
Especies invasoras, un agujero millonario
martes, 16 de febrero de 2016
Una impresora 3D crea huesos, músculos y cartílagos
Una impresora 3D crea huesos, músculos y cartílagos
Las estructuras impresas han mostrado su viabilidad estructural y funcional en animales
Los diccionarios tecnológicos tienen que ir haciendo hueco a un nuevo término: la bioimpresión. Usando una impresora 3D creada por ellos, un grupo de especialistas en medicina regenerativa de EE UU ha demostrado la viabilidad de tejidos vivos impresos. Con el mismo sistema imprimieron huesos, cartílagos y músculos que después implantaron en modelos animales. En un porcentaje superior al 90%, las estructuras impresas regeneraron el tejido, creando su propio sistema vascular.
La ingeniería de tejidos es una de las grandes promesas de la medicina regenerativa. En un futuro, tras escanear la zona u órgano dañada, un programa modelará la estructura y tejidos a imprimir y una impresora 3D que usa células en vez de tinta obrará el milagro. Ya hay empresas que comercializan tejidos celulares sacados por la impresora, como Organovo. Pero restaurar una parte del cuerpo defectuosa o dañada por un accidente exige una tecnología que aún no ha llegado pero que la ciencia está acercando paso a paso.
El último de estos avances lo ha dado el grupo de investigación en medicina regenerativa del Centro Médico Baptista Wake Forest (Winston-Salem, EE UU). Dirigidos por Anthony Atala, han creado una impresora de material vivo o bioimpresora. Su nombre o siglas es ITOP, o sistema integrado de impresión de tejidos y órganos, en inglés. El artilugio es algo aparatoso, pero no más que otras impresoras 3D de uso industrial. Pero ITOP imprime estructuras vivas en vez de cosas.
"Esta nueva impresora de tejidos y órganos es un importante avance en nuestro objetivo de crear tejido de reemplazo para los pacientes, dice en una nota el doctor Atala, que ya hace unos años consiguió crear cartílago con una impresora de inyección de tinta. Ahora han perfeccionado el sistema. "Puede fabricar tejidos a escala humana de cualquier forma y estables. Con su desarrollo, esta tecnología podría usarse para imprimir estructuras de tejidos y órganos para su implantación quirúrgica", añade.
En 2012, este equipo de investigadores imprimió cartílago con una impresora de inyección
ITOP parte de aquellos primeros trabajos. La impresora realiza un doble proceso. Por un lado, usa polímeros para recrear una matriz con la estructura básica del tejido a imprimir. Por el otro, sobre esa estructura inyecta un hidrogel enriquecido con las células de interés. Por ejemplo, precursores de las fibras musculares, mioblastos, para imprimir un músculo, o condrocitos si lo que se trata es de crear una oreja u otro tejido cartilaginoso. Los investigadores usaron también células madre procedentes de líquido amniótico humano como base para imprimir una mandíbula o una porción del cráneo.
El principal problema hasta ahora en este punto del proceso era conseguir que el biomaterial impreso no solo se mantuviera vivo, sino que sirviera de base para que las células proliferaran a lo largo de la estructura. Según los resultados de su investigación, publicada en Nature Biotechnology, tanto las células usadas para el tejido muscular, como los de huesos o las de la oreja seguían vivas seis días después de su impresión y habían iniciado procesos de proliferación celular.
Lo siguiente fue probar su viabilidad tanto estructural como funcional. Cada una de las impresiones fue implantada en diferentes modelos animales, ratas y ratones. En los cuatro casos, la supervivencia celular superó el 90% y en todos ellos, los tejidos impresos fueron capaces de proliferar, generando nuevo tejido. Una de las claves para esta regeneración parece haber sido la inclusión de microcanales dentro la estructura impresa que, como si fuera un sistema vascular propio, permitieron la circulación del oxígeno y los nutrientes.
"Nuestros resultados indican que la formulación de biotintas que hemos usado, combinado con los microcanales, ofrece el ambiente adecuado para mantener las células vivas y soportar el crecimiento celular y de los tejidos", explica Atala. Aún queda lo más difícil, repetir estos resultados con humanos. Pero el Ejército de EE UU, que es el que ha financiado esta investigación por sus grandes posibilidades con los heridos de guerra, está decidido a que la impresora de huesos sea una realidad.
MÁS INFORMACIÓN
Sanidad y la Sociedad Española de Ginecología y Obstetricia acuerdan un protocolo de seguimiento en relación al virus zika en el embarazo
- Aprobado por la Comisión de Salud
Pública
- Se realizarán ecografías seriadas cada
dos semanas a las embarazadas con diagnóstico de virus zika
- Las gestantes con sintomatología
compatible con el virus tras haber viajado a zonas con transmisión
autóctona se realizarán análisis de orina y sangre para descartar la
presencia del virus
- Se mantiene la recomendación a mujeres
embarazadas o con intención de quedarse embarazadas para que pospongan, en
lo posible, los viajes a zonas afectadas
viernes, 12 de febrero de 2016
Mueren 12 menores indígenas por rabia en Perú
Al menos 12 niños indígenas murieron en Perú tras ser mordidos por murciélagos hematófagos infectados de rabia entre septiembre y febrero en dos comunidades nativas de la amazónica región Loreto, frontera con Ecuador, informó ayer el Ministerio de Salud.
"Por los síntomas y los reportes médicos se determinó que los 12 niños de dos comunidades de la etnia Achuar murieron por un brote de rabia silvestre", dijo el director de Salud en Loreto, Hermann Silva.
"Las víctimas fueron mordidas por murciélagos hematófagos, animales que se alimentan de sangre, en las comunidades de Yankuntich y Uncun en la selva de la región Loreto, mil 100 kilómetros al norte de Lima, indicó el especialista.
Los menores fallecidos tenían entre 8 y 15 años de edad. Los decesos ocurrieron entre septiembre de 2015 y febrero, según las autoridades sanitarias.
El último menor fallecido se reportó ayer en el hospital Regional de Loreto.
"Hemos conversado con los Apus (autoridades nativas) y ellos nos reportaron que la comunidad creía que la muerte de esos niños se debía a brujería, es por eso que no nos informaron a tiempo del brote de rabia", indicó Silva, quien viajó a ambas comunidades achuares ubicadas en la provincia Datem del Marañón en la frontera con Ecuador.
Silva informó que brigadas de vacunación han sido enviadas de urgencia para atender a las poblaciones afectadas que viven en zonas remotas a las que se llega tras viajes de varias horas por los ríos de la selva o en helicóptero.
"Estamos enviando siete mil dosis de vacunas para aplicar a las comunidades nativas", indicó el médico.
Por su parte, el gobernador de la región Loreto, Fernando Meléndez, pidió al gobierno del presidente Ollanta Humala que declarara la emergencia sanitaria en su región.
Fuente http://www.excelsior.com.mx/global/2016/02/11/1074377
Microsoft presenta aplicación que identifica la raza de un perro
Usando inteligencia artificial es posible determinar la edad de una persona, su sexo, su estado de ánimo.. incluso la raza de un perro.
Así lo demuestra el nuevo proyecto de microsoft, proyecto que presentan en este artículo y causante de una aplicación web y una aplicación iOS que podemos usar hoy mismo.
La versión web, disponible en what-dog.net, funciona de forma muy sencilla: subimos la foto de nuestro perro y esperamos a que los servidores de Microsoft comparen los rasgos con las miles de imágenes clasificadas que ya tienen, obteniendo coincidencias y resultados en muy pocos segundos.
Además de indicar la raza en cuestión (con mi perra ha dado mil resultados diferentes, ya que no tiene raza definida), mostrará las características de la misma: si es amigable, si le gusta correr o se pasa la vida durmiendo, etc.
aplicación adivina raza de perro
Sigue la linea de los ya comentados HowOld.net, TwinsOrNot.net o MyMoustache.net: proyectos sencillos para demostrar que los ordenadores están aprendiendo rápido, que cada vez son más capaces de llegar a conclusiones válidas a partir de imágenes, y de reducir el porcentaje de error a medida que aprenden con la propia experiencia.
Desde su web tenéis también el link a la versión iOS, aunque no han comentado nada sobre una supuesta versión android.
Fuente http://wwwhatsnew.com/2016/02/11/microsoft-presenta-aplicacion-que-identifica-la-raza-de-un-perro/
La ordenanza de protección animal prevé multas de hasta 3.000 euros
El nuevo texto fija la creación de un censo de mascotas y limita la permanencia de animales en casas deshabitadas
Las multas oscilarán entre los 50 euros y los 3.000 euros. La formación Izquierda Unida-Los Verdes sacó adelante su propuesta sobre la ordenanza municipal de Abarán para la protección animal, que recogerá los principios básicos de respeto, defensa, protección, higiene y salubridad de los animales de compañía. La iniciativa dividió a los grupos municipales y su aprobación generó un intenso debate entre los partidos.
El PP se abstuvo y propuso posponer esta normativa hasta la aprobación definitiva de la ley regional. UYD también se opuso. Pero la iniciativa salió adelante con el apoyo de PSOE y Ciudadanos.
Las infracciones en materia de sanidad, según contempla el nuevo texto, serán leves, graves o muy graves, y las sanciones oscilarán entre 50 y 300 euros; de 300 a 1.500 euros y de 1.500 a 3.000 euros, respectivamente. Los propietarios de animales potencialmente peligrosos tendrán la obligación de comunicarlo a los servicios sanitarios. Las mascotas abandonadas deberán ser recogidas por una entidad colaboradora. Las competencias de esta ordenanza municipal, que consta de un total de 63 artículos, quedan atribuidas a las concejalías de Medio Ambiente, Sanidad y Consumo. Para ello se creará un censo municipal de animales de compañía en colaboración con el sistema de identificación de animales de compañía de la Región (Siamu).
La normativa prohibe la permanencia de animales en viviendas no habitadas cuando exista denuncia por no tenerlos en condiciones higiénicas y sanitarias adecuadas, así como cuando existan varias denuncias por ruidos. También impide la circulación por las vías públicas de aquellos perros que no vayan provistos de identificación censal.
viernes, 5 de febrero de 2016
Toxoplasmosis: prevención y cuidados
Toxoplasmosis: prevención y cuidados
Es una enfermedad con impacto directo en la salud pública, ya que puede afectar a la mujer en el momento del embarazo.
Vivimos en una sociedad muy tecnificada con grandes adelantos y muchas más comodidades de las que vivieron nuestros padres e incluso nuestros abuelos, pero junto a estos progresos nos hemos vuelto fríos y deshumanizados. Tal vez por ello, el mundo de las mascotas (grandes o pequeñas) está creciendo de manera vertiginosa. ¿El motivo? Nos aportan el valor incomparable de su compañía, fidelidad y el cariño a toda prueba.
Junto a ellos está la figura del veterinario, él garantiza la salud de su animal de compañía y al mismo tiempo la suya propia y la de su familia, al ser este conocedor de las zoonosis, es decir para entendernos: de aquellas enfermedades de transmisión desde los animales al ser humano.Hoy vamos a hablar de una de ellas la Toxoplasmosis.
Por desgracia existen más como la tiña, sarna, quiste hidatídico, leptospirosis, Rabia, Salmonelosis, Brucelosis y otras, que trataremos de contar; pero ojo sin que cunda la alarma. Todas estas enfermedades pueden tener solución si se acude al veterinario y se cumplen las normas básicas para mantener a nuestra mascota feliz y lo más importante -tanto para ella como para los que conviven con ella- sana.
Tipo de riesgo
Al mencionar Toxoplasmosis, de inmediato las miradas se vuelven, casi de manera infalible, hacia el gato de la casa. Casi todo el mundo sabe que este puede estar implicado y se convirte inexorablemente en sospechoso. En palabras del doctor Javier Álvarez de la Villa, «los veterinarios intentamos aportar la suficiente información que elimine al cien por cien cualquier tipo de riesgo» - y añade- «Es cierto, que la especie felina actúa como huésped definitivo del agente productor denominado Toxoplasma gondii.
Este protozoo se desarrolla en los gatos y es en el intestino de nuestro gato donde completa su ciclo, que termina eliminando huevos (oocistos) con capacidad infestante». Estos huevos contaminarán las aguas, los campos de cultivo, los pastos, dando oportunidad a que roedores, aves, ovejas, cabras, cabras y cerdos se contaminen. En estos animales, el microbioinvade su organismo. Se produce el contagio en el ser humano al ingerir carne poco cocinada. De hecho esta sería la principal vía de contagio y NO nuestro gato doméstico.
Lavar bien las verduras
Una segunda vía se establece con ingestión de verduras mal lavadas. La tercera vía sería por convivencia con un gato portador y eliminador. Esta última posibilidad, es normalmente la más remota, pero es necesario desactivarla al 100% . Su veterinario habitual conoce perfectamente el protocolo de actuación eliminando totalmente la desconfianza y miedo que normalmente aporta la desinformación.
Javier Álvarez de la Villa http://www.centroveterinariovictordelaserna.com/) comenta que no hay motivos para alarmas y que hay que seguir un protocolo: Primeramente se realiza la prueba de anticuerpos en el suero de nuestra mascota. Casi siempre los resultados serán normales... ¿El motivo? «nuestro felino no caza ratones, ni pájaros, ni come cucarachas, ni lombrices, ni su dueño le alimenta con carne cruda. Es decir, que al vivir en un piso y alimentarse de manera exclusiva de piensos y alimentos comerciales es de todo imposible que sea portador».
Otro caso es el gato que tiene acceso al jardín donde puede cazar o contactar con gatos vagabundos. En estas situaciones el peligro potencialmente es mayor y como queremos seguridad hay que acudir al veterinario para realizarle una prueba a modo de prevención. Si el gato está libre de la condición de portador, es decir, que no contiene y elimina toxoplasma será momento idóneo para evitarle todo aquello que le pueda contaminar que como sabemos, incluiría la predación (evitar que cace), el contacto con gatos vagabundos, el acceso a carnes y alimentos crudos.
Si por el contrario nos encontramos con un gato positivo, es necesario constatar mediante un análisis coprológico (estudio en el laboratorio de muestras fecales) si es eliminador de oocistos. En este último caso, nuestro veterinario consultado nos comenta que «se trataría de manera adecuada para convertirlo en una mascota segura. Como vemos, no siempre el gato es el culpable. De esta manera se evitarán muchos abandonos de nuestras, a veces injustamente estigmatizadas mascotas».
Huésped pero no culpable
Es cierto, que es el único húesped definitivo, pero eso no le convierte en absoluto en culpable pues la mayoría de las infestaciones acontecen como hemos visto por la ingestión de carnes que por costumbre se consumen al punto o poco hechas y de hortalizas mal procesadas o poco lavadas.
El gato al que se le ha hecho una analítica que permita comprobar la presencia de anticuerpos en sangre, alimentado de manera adecuada con comida (seca o húmeda de la que se vende en tiendas de mascotas y grandes superficies) y con hábitos adecuados es absolutamente inofensivo e inocuo como transmisor de la toxoplasmosis.
A modo de recordatorio...
Les recordamos una serie de puntos a modo de prevención:
-Laven bien las hortalizas, cocinen las carnes a altas temperaturas y tiempo suficiente.
-Alimente siempre a su gato con alimentos comerciales.
-Eviten la caza por parte de su gato
-Evite el contacto con gatos vagabundos pues desgraciadamente no están controlados por veterinarios y constituyen población de riesgo.
-Realice labores de jardinería con guantes y siempre lavarse las manos a conciencia.
-Cambie el arenero a diario pues antes de 24 horas los oocistos no son infestantes. Absténgase de realizar esta labor la mujer embarazada.
-Finalmente recuerde acudir a su veterinario y ante cualquier duda él le explicará todas estas informaciones, a fin de convivir con nuestras mascotas de manera totalmente segura.
Fuente : http://www.abc.es/sociedad/abci-toxoplasmosis-prevencion-y-cuidados-201602032226_noticia.html

